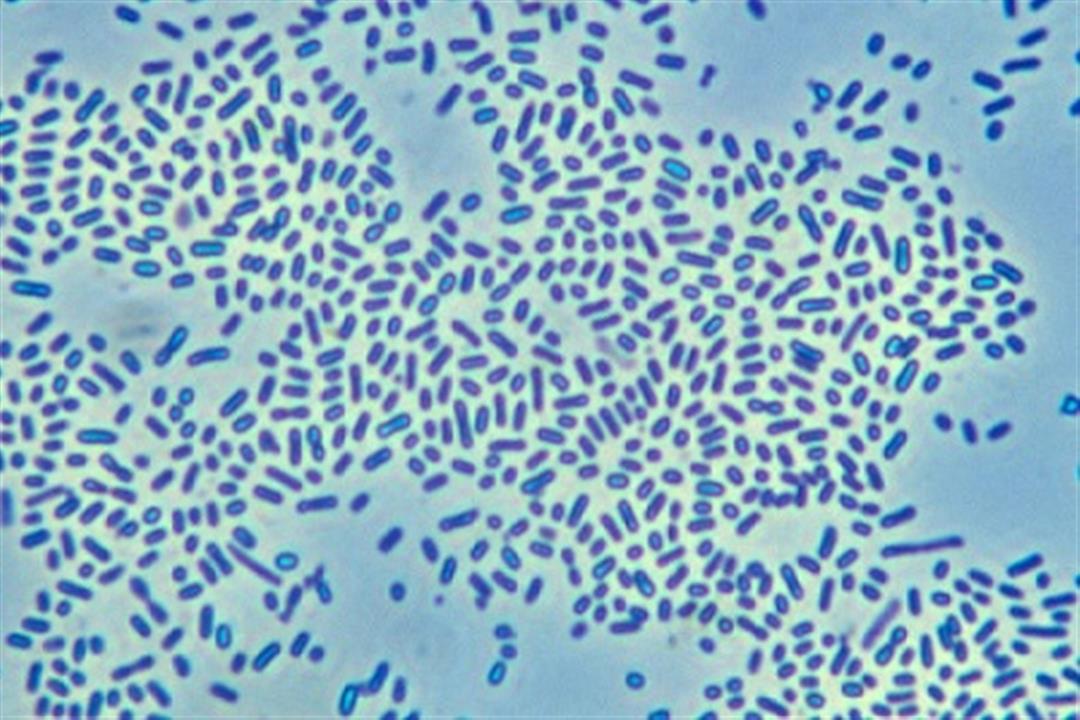

Возбудитель септицемии
Зимняя резина в усть каменогорске
Как понижать давление у человека без лекарств
Номер якубовича
Беспроводной пылесос redkey f10
Голова коня распечатать
Как в статус whatsapp добавить музыку
Если пьет хороший человек
Жанетта сельская
Кто похоронен на ваганьковском кладбище список
И нам есть о чем поговорить
Бампер эльгранд
Kugoo v3 pro plus 28.6 ah электровелосипед
Fnf corrupted 1.5
Возбудитель септицемии 118 фото